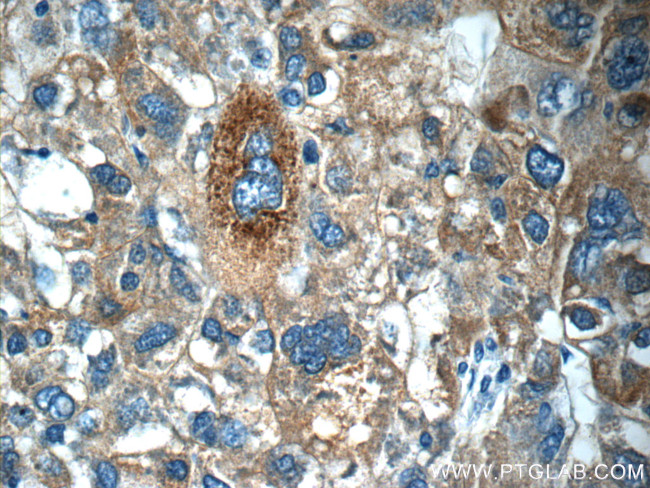
C4BPA Antibody in Immunohistochemistry (Paraffin) (IHC (P))

Search
Proteintech
C4BPA Polyclonal Antibody
{{$productOrderCtrl.translations['antibody.pdp.commerceCard.promotion.promotions']}}
{{$productOrderCtrl.translations['antibody.pdp.commerceCard.promotion.viewpromo']}}
{{$productOrderCtrl.translations['antibody.pdp.commerceCard.promotion.promocode']}}: {{promo.promoCode}} {{promo.promoTitle}} {{promo.promoDescription}}. {{$productOrderCtrl.translations['antibody.pdp.commerceCard.promotion.learnmore']}}
产品信息
11819-1-AP
种属反应
已发表种属
宿主/亚型
分类
类型
抗原
偶联物
形式
浓度
规格
纯化类型
保存液
内含物
保存条件
运输条件
产品详细信息
C4BP is composed of two polypeptides (alpha and beta chains), which have molecular weights of 70 and 45 kDa, respectively. This polyclonal antibody is raised against the C4BP alpha chain (C4BPA).
Immunogen sequence: PSPPACEPN SCINLPDIPH ASWETYPRPT KEDVYVVGTV LRYRCHPGYK PTTDEPTTVI CQKNLRWTPY QGCEALCCPE PKLNNGEITQ HRKSRPANHC VYFYGDEISF SCHETSRFSA ICQGDGTWSP RTPSCGDICN FPPKIAHGHY KQSSSYSFFK EEIIYECDKG YILVGQAKLS CSYSHWSAPA PQCKALCRKP ELVNGRLSVD KDQYVEPENV TIQCDSGYGV VGPQSITCSG NRTWYPEVPK CEWETPEGCE QVLTGKRLMQ CLPNPEDVKM ALEVYKLSLE IEQLELQRDS ARQSTLDKEL (289-597 aa encoded by BC022312)
靶标信息
There are 3 variants of Complement component 4 binding protein (C4bp), which is composed of alpha and beta chains. The predominant form is a 570 kDa complex of 7 alpha chains and 1 beta chain. The other complexes formed are a 530 kDa homoheptamer of alpha chains or a 500 kDa complex of 6 alpha chains and 1 beta chain. C4bp regulates the activation of the classical complement pathway. It is a cofactor to the C3b/C4b inactivator, crucial to the proteolytic cleavage of C4b and important in cleavage of C3b. C4bp also regulates the C4bC2a complex (C3 convertase), accelerating its degradation by dissociating the complement fragment C2a. Both the C4bp alpha and beta chains interact with anticoagulant protein S and C4bp alpha binds protein S. C4bp is expressed in the blood serum.
仅用于科研。不用于诊断过程。未经明确授权不得转售。
生物信息学
蛋白别名: C4b-binding protein alpha chain; C4bp; Proline-rich protein; PRP; RP11-164O23.4; unnamed protein product
基因别名: C4BP; C4BPA; PRP
UniProt ID: (Human) P04003
Entrez Gene ID: (Human) 722